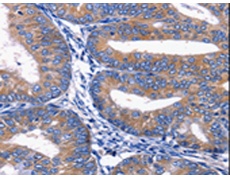
一抗

中文名稱: 兔抗PLEKHO1多克隆抗體
英文名稱: Anti-PLEKHO1 rabbit polyclonal antibody
別 名: OC120; CKIP-1
相關(guān)類別: 一抗
抗 原: PLEKHO1
儲(chǔ) 存: 冷凍(-20℃)
宿 主: Rabbit
反應(yīng)種屬: Human, Mouse, Rat
標(biāo) 記 物: Unconjugate
克隆類型: rabbit polyclonal
技術(shù)規(guī)格
|
Background: |
Pleckstrin homology domain-containing family O member 1 is a protein that in humans is encoded by the PLEKHO1 gene.PLEKHO1 has been shown to interact with Casein kinase 2, alpha 1 and SMURF1.It plays a role in the regulation of the actin cytoskeleton through its interactions with actin capping protein (CP). Appears to target ATM to the plasma membrane,and also inhibit tumor cell growth by inhibiting AKT-mediated cell-survival. The protein implicated in PI3K-regulated muscle differentiation, the regulation of AP-1 activity (plasma membrane bound AP-1 regulator that translocates to the nucleus) and the promotion of apoptosis induced by tumor necrosis factor TNF. When bound to PKB, it inhibits it probably by decreasing PKB level of phosphorylation. |
|
Applications: |
ELISA, IHC |
|
Name of antibody: |
PLEKHO1 |
|
Immunogen: |
Synthetic peptide of human PLEKHO1 |
|
Full name: |
pleckstrin homology domain containing, family O member 1 |
|
Synonyms: |
OC120; CKIP-1 |
|
SwissProt: |
Q53GL0 |
|
ELISA Recommended dilution: |
1000-5000 |
|
IHC positive control: |
Human cervical cancer |
|
IHC Recommend dilution: |
25-100 |

 購物車
購物車 幫助
幫助
 021-54845833/15800441009
021-54845833/15800441009